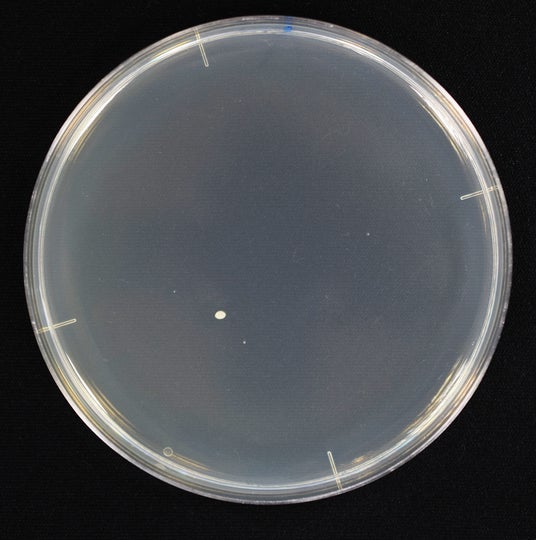
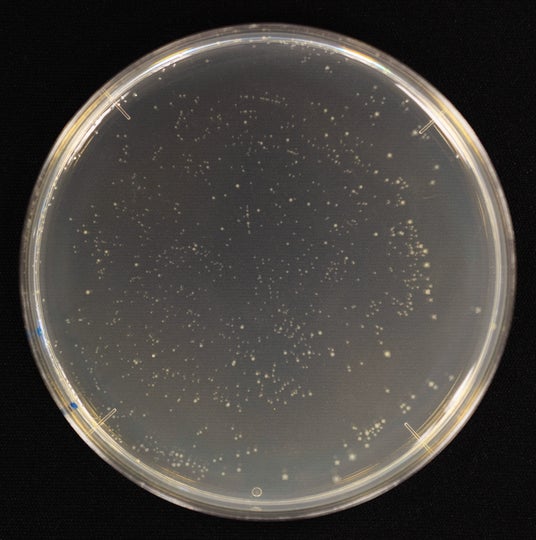

連日の猛暑を乗り切る!夏場の水分補給の基本を解説 夏は飲みかけの飲料に要注意!? 飲みものの温度上昇に伴い菌数が増加
魔法びんのグローバル企業として、人と社会に快適で環境にもやさしいライフスタイルを提案するサーモス株式会社(本社:東京都港区 社長:片岡 有二)は、2025年8月5日(火)に開催した秋冬新製品発表会にて、プレスセミナー「夏場に役立つ!外出時の水分補給術」を開催しました。
当日は、赤坂ファミリークリニック院長で小児科医の伊藤明子先生を講師に迎え、記録的な猛暑が続く今夏における熱中症対策としての“外出時における正しい水分補給術”について、最新データや医学的視点を交えて解説しました。
■夏場の水分補給の基本を解説
連日の異常な暑さにより、全国的に熱中症患者が増加しています。熱中症による救急搬送者数も増加傾向にあり、前年同期間比で1.6倍に達した日もありました(※1)。こうした状況を踏まえ、伊藤明子先生は「昨今の異常気象により猛暑は年々厳しさを増しており、命を守るための熱中症対策は不可欠。今年の6月から建設現場や農作業などでの熱中症対策が法的義務化され、熱中症対策は個人の努力ではなく義務として定められるほどになり、正しい知識に基づく対策が求められます(※2)」と説明。「中でも水分補給は最も重要です」と強調し、夏場における水分補給の基本を解説しました。

赤坂ファミリークリニック 院長 伊藤明子先生
(※1):総務省消防庁「熱中症による救急搬送人員」
集計期間(5月1日~7月6日):2024年(確定値)・2025年(速報値)比較
(※2):厚生労働省「職場における熱中症対策の強化について」
■暑い環境では外出時の飲みものの温度は、どんどん上がる
猛暑下(35 ℃)で飲みかけの飲料(ペットボトル・水筒)の菌数について実験
記録的な暑さが続く中、熱中症を防ぐにはこまめな水分補給が欠かせません。一方で、夏場に飲みものを持ち歩く際には温度上昇と衛生面への配慮が必要です。真夏の猛暑下(35℃)では、飲料の温度は時間とともに急速に上昇します。
2025年7月に実施した「サーモス 飲料・容器別 生菌数に関する調査(*)」によると、室温35℃で静置したペットボトル飲料は、飲料温度が31.9℃まで上昇しました。同条件でスポーツドリンクの菌数を測定したところ、9時間後にはペットボトルで約4億3千万 CFUに達したのに対し、保冷ができる真空断熱構造の水筒では約1万1千 CFUにとどまり、その差は約3万倍に及びました。
この結果について伊藤明子先生は「飲料に含まれる糖分や食物繊維は菌のエサとなり、温度上昇に伴い菌数が増加する傾向があります。外出時は飲みものの温度管理を徹底し、ステンレス製魔法びん構造で保冷ができる水筒を活用して増殖を防ぎましょう」と注意を呼びかけました。
<実験概要>(*)
調査名:『サーモス 飲料・容器別 生菌数に関する調査』
(調査機関:株式会社衛生微生物研究センター)
調査期間:2025年7月
調査条件:
・冷蔵庫で4℃に冷却したペットボトル飲料(スポーツドリンク/500ml)、氷を入れて冷えた飲料(スポーツドリンク)を注いだ真空断熱構造の水筒(500ml)を比較。
・測定開始前に、唾液0.5ml追加したのちに、ペットボトル、水筒を室温35℃に静置。
・菌数は、唾液添加直後の0時間、6時間、9時間のポイントで測定。
◇スポーツドリンク(水筒・ペットボトルの菌数・温度推移)

『サーモス 飲料・容器別 生菌数に関する調査』(調査機関:株式会社衛生微生物研究センター)
◇スポーツドリンク内の菌数増殖 ー ステンレス製魔法びん構造の水筒とペットボトルの比較
ステンレス製魔法びん構造の水筒内の菌数(9時間後) ペットボトル内の菌数(9時間後)
9時間後:1万1千(CFU)
9時間後:4億3千万(CFU)
■外出時の水分補給で押さえるべき “3つのポイント”
今回実施した実験結果から今夏の異常な暑さにおける外出時の水分補給で押さえるべき“3つのポイント”を紹介しました。
1. 温度に要注意
冷蔵庫で冷やすことができない外出時は飲みものの温度がどんどん上昇します。雑菌を増やさないためにも飲みものの温度管理をしっかりしましょう。また外出時間が長くなる場合は、ステンレス製魔法びん構造の保冷機能がある水筒を活用しましょう。
2. 飲みものの成分と時間に注意!
糖分や食物繊維は菌の栄養源となるため、飲料の温度が上昇すると菌が急速に繁殖しやすくなります。スポーツドリンクだけでなく、糖分を多く含むジュースや、食物繊維が入った麦茶も同様に雑菌が増えやすいです。外出時に飲みを持ち運ぶ際は、飲料に含まれる成分と持ち歩く時間に注意し、できるだけ早めに飲み切るか保冷して衛生管理を徹底しましょう。
3. 選び方に要注意
カフェインを多く含むコーヒーや紅茶、緑茶は利尿作用が強いため、外出時の水分補給には適していません。また、甘い炭酸飲料も、高濃度の糖分を摂取することとなり、水分補給の妨げや脱水を招く可能性があります。いずれも飲み過ぎには注意しましょう。

■講師プロフィール赤坂ファミリークリニック 院長
小児科医、日本公衆衛生学会認定社会医学系専門医
伊藤 明子(いとう みつこ)先生
日本公衆衛生学会認定社会医学系専門医。
東京大学医学部附属病院 医師。
NPO法人Healthy Children, Healthy Lives代表理事。
同時通訳を経て小児科医へ転身した異色のキャリア。食と栄養の研究論文複数出版。『医師が教える子どもの食事』など一般向けの子どもの食事と栄養に関する著書を複数執筆している。
【サーモスブランド】
1904年、ドイツで誕生。世界で初めてガラス製魔法びんを製品化し、1978年には日本の技術力をもって世界初の「高真空ステンレス製魔法びん」を生み出した、世界最大の魔法びんブランドです。魔法びんのパイオニアとして世界120ヵ国以上で愛される存在です。
https://www.thermos.jp/company/history/
【サーモス株式会社】
サーモス株式会社は、魔法びんのグローバル企業として、ステンレス製魔法びん構造のケータイマグやタンブラー、スープジャーの他、フライパンなどの調理器具といった幅広いラインアップを展開。断熱技術をはじめとしたさまざまな技術と創造力で、人と社会に快適で環境にもやさしいライフスタイルを提案しています。https://www.thermos.jp/
※サーモス株式会社は、日本酸素ホールディングスグループの一員です。
製品に関するお問い合わせ先
サーモスお客様相談室
TEL(ナビダイヤル):0570-066966 https://www.thermos.jp/